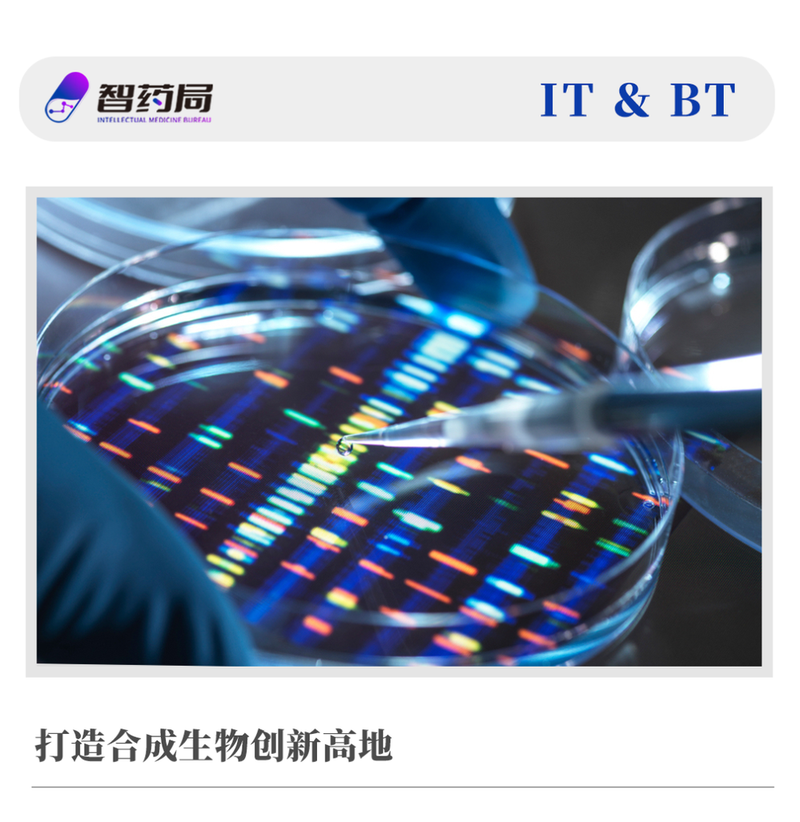
图片

近日,上海市科委发布《关于发布上海市2024年度“科技创新行动计划”合成生物学领域项目申报指南的通知》。
本次共有16个课题入选“科技创新行动计划”合成生物领域项目,市科委资助3700万元,其中2024年拨款2960万元。
复旦大学、上海交通大学、华东理工大学等多个科研项目入选,同时百开盛、弈柯莱、新兴际华等多个公司和产业项目入围。

3700万,16个合成生物学项目。它们不仅代表了上海市对合成生物前沿科研项目和产业落地的支持,更是代表上海市成为合成生物创新引擎的决心。
打造合成生物创新高地
上海市“科技创新行动计划”由上海市政府拨款,上海市科学技术委员会管理和实施,目标是将上海建设成具有全球影响力的科技创新中心。
文件显示,2024年上海市科技创新计划专项资金为38.7亿元。
显然,这一轮全国性的合成生物产业竞争中,上海市在土地和能源不占优势的情况下,选择以技术和创新力作为核心竞争力,同时提高国际化的竞争力。
2023年,上海市发布《上海市加快合成生物创新策源,打造高端生物制造产业集群行动方案(2023-2025年)》。
该《行动方案》中指出,到2025年要新增有国际影响力的顶尖科学家及团队5个以上,建立库容百万级以上的元件库,同时吸引5家以上企业区域或研发总部。
就在同一年,为了适应产业发展变化和交叉学科趋势,上海市科委设立了合成生物学、计算生物学等重点专项,助力行业的快速发展。
通过这些项目,上海市“科技创新行动计划”布局了包含计算生物学、生物医药创新发展、创新药械产品、新能源领域技术、细胞与基因治疗、超导等多个前沿领域。
拥有扎实的高校资源和创新基因,也让上海逐步将科研能力转化为产业资源,并且以强大的产业配套帮助企业建设和融资。
例如本次两个项目入选的百开盛(上海)生物科技有限公司,由华东理工大学鲁华生物技术研究所创始人魏东芝教授领衔成立,公司旗下已经有角鲨烷、依克多因、麦角硫因等多个产品落地。
今年10月底,由上海交通大学科技成果转化的合成生物企业肆芃科技完成近亿元Pre-A轮融资,本轮投资由国投创合领投、如皋科创投跟投。
该公司依托于上海市市级科技重大专项及新加坡国家基金会资助的CNSB重大项目,打造多款生物基材料,已经和安琪酵母集团建立深度合作。
2023年,在上海市科委的支持与指导下,由赵国屏院士及其团队与张江集团共同发起,“上海合成生物学创新中心”在浦东正式揭牌。

该创新中心的目标是依托上海在合成生物学领域的深厚科研实力,通过与国内外科研机构、非盈利组织、领军企业等广泛合作,开展合成生物领域人才网络搭建、技术合作、概念验证、科技成果转化等工作。
作为成果之一,合成生物上市公司嘉必优已经和上海合成生物学创新中心高价值分子平台合作签约。
如今,上海已经集结了包括凯赛生物、蓝晶微生物、弈柯莱、赢迪生物等一批合成生物重点企业,这些企业绝大多数将总部和研发中心设立在上海。
卷平台,卷政策
不止上海,在各地掀起的促进合成生物产业发展的浪潮中,北京、深圳、天津等地都形成了重量级的科研平台,并以此作为产业策源中心。
早在2014年,中国科学院深圳先进技术研究院就组建了合成生物学工程研究中心,而后发展为国内首个合成生物学研究所,多达1200余人。
此外,深圳市科技创新局在科技重大专项中设立了合成生物学板块,以每年1亿元专项基金资助合成生物企业的核心技术突破,资助金额为200万—1000万。
深圳市光明区还设立了合成生物企业资助项目,按照不同的认定标准,对于合成生物公司一次性给予最高200万元奖励。
在天津,政府不仅牵头成立了中国科学院天津工业生物技术研究所,在业界拥有巨大的影响力,同时天津大学、天津药物研究院、天津科技大学也正在推动生物制造的创新发展。
在天津市政府《加快合成生物创新策源推动生物制造产业高质量发展实施方案的通知》中提到,将打造国家级中试平台,新增2至3个生物制造领域国家级创新平台。
而杭州市发布的《杭州合成生物学产业核心区高质量发展试点政策》中明确提出,将打造杭州合成生物学学科高地。
对合成生物学重点技术攻关任务,杭州将给予最高3000万元支持;合成生物学产业项目提升改造的,最高给予1亿元的资助资金。
—The End—